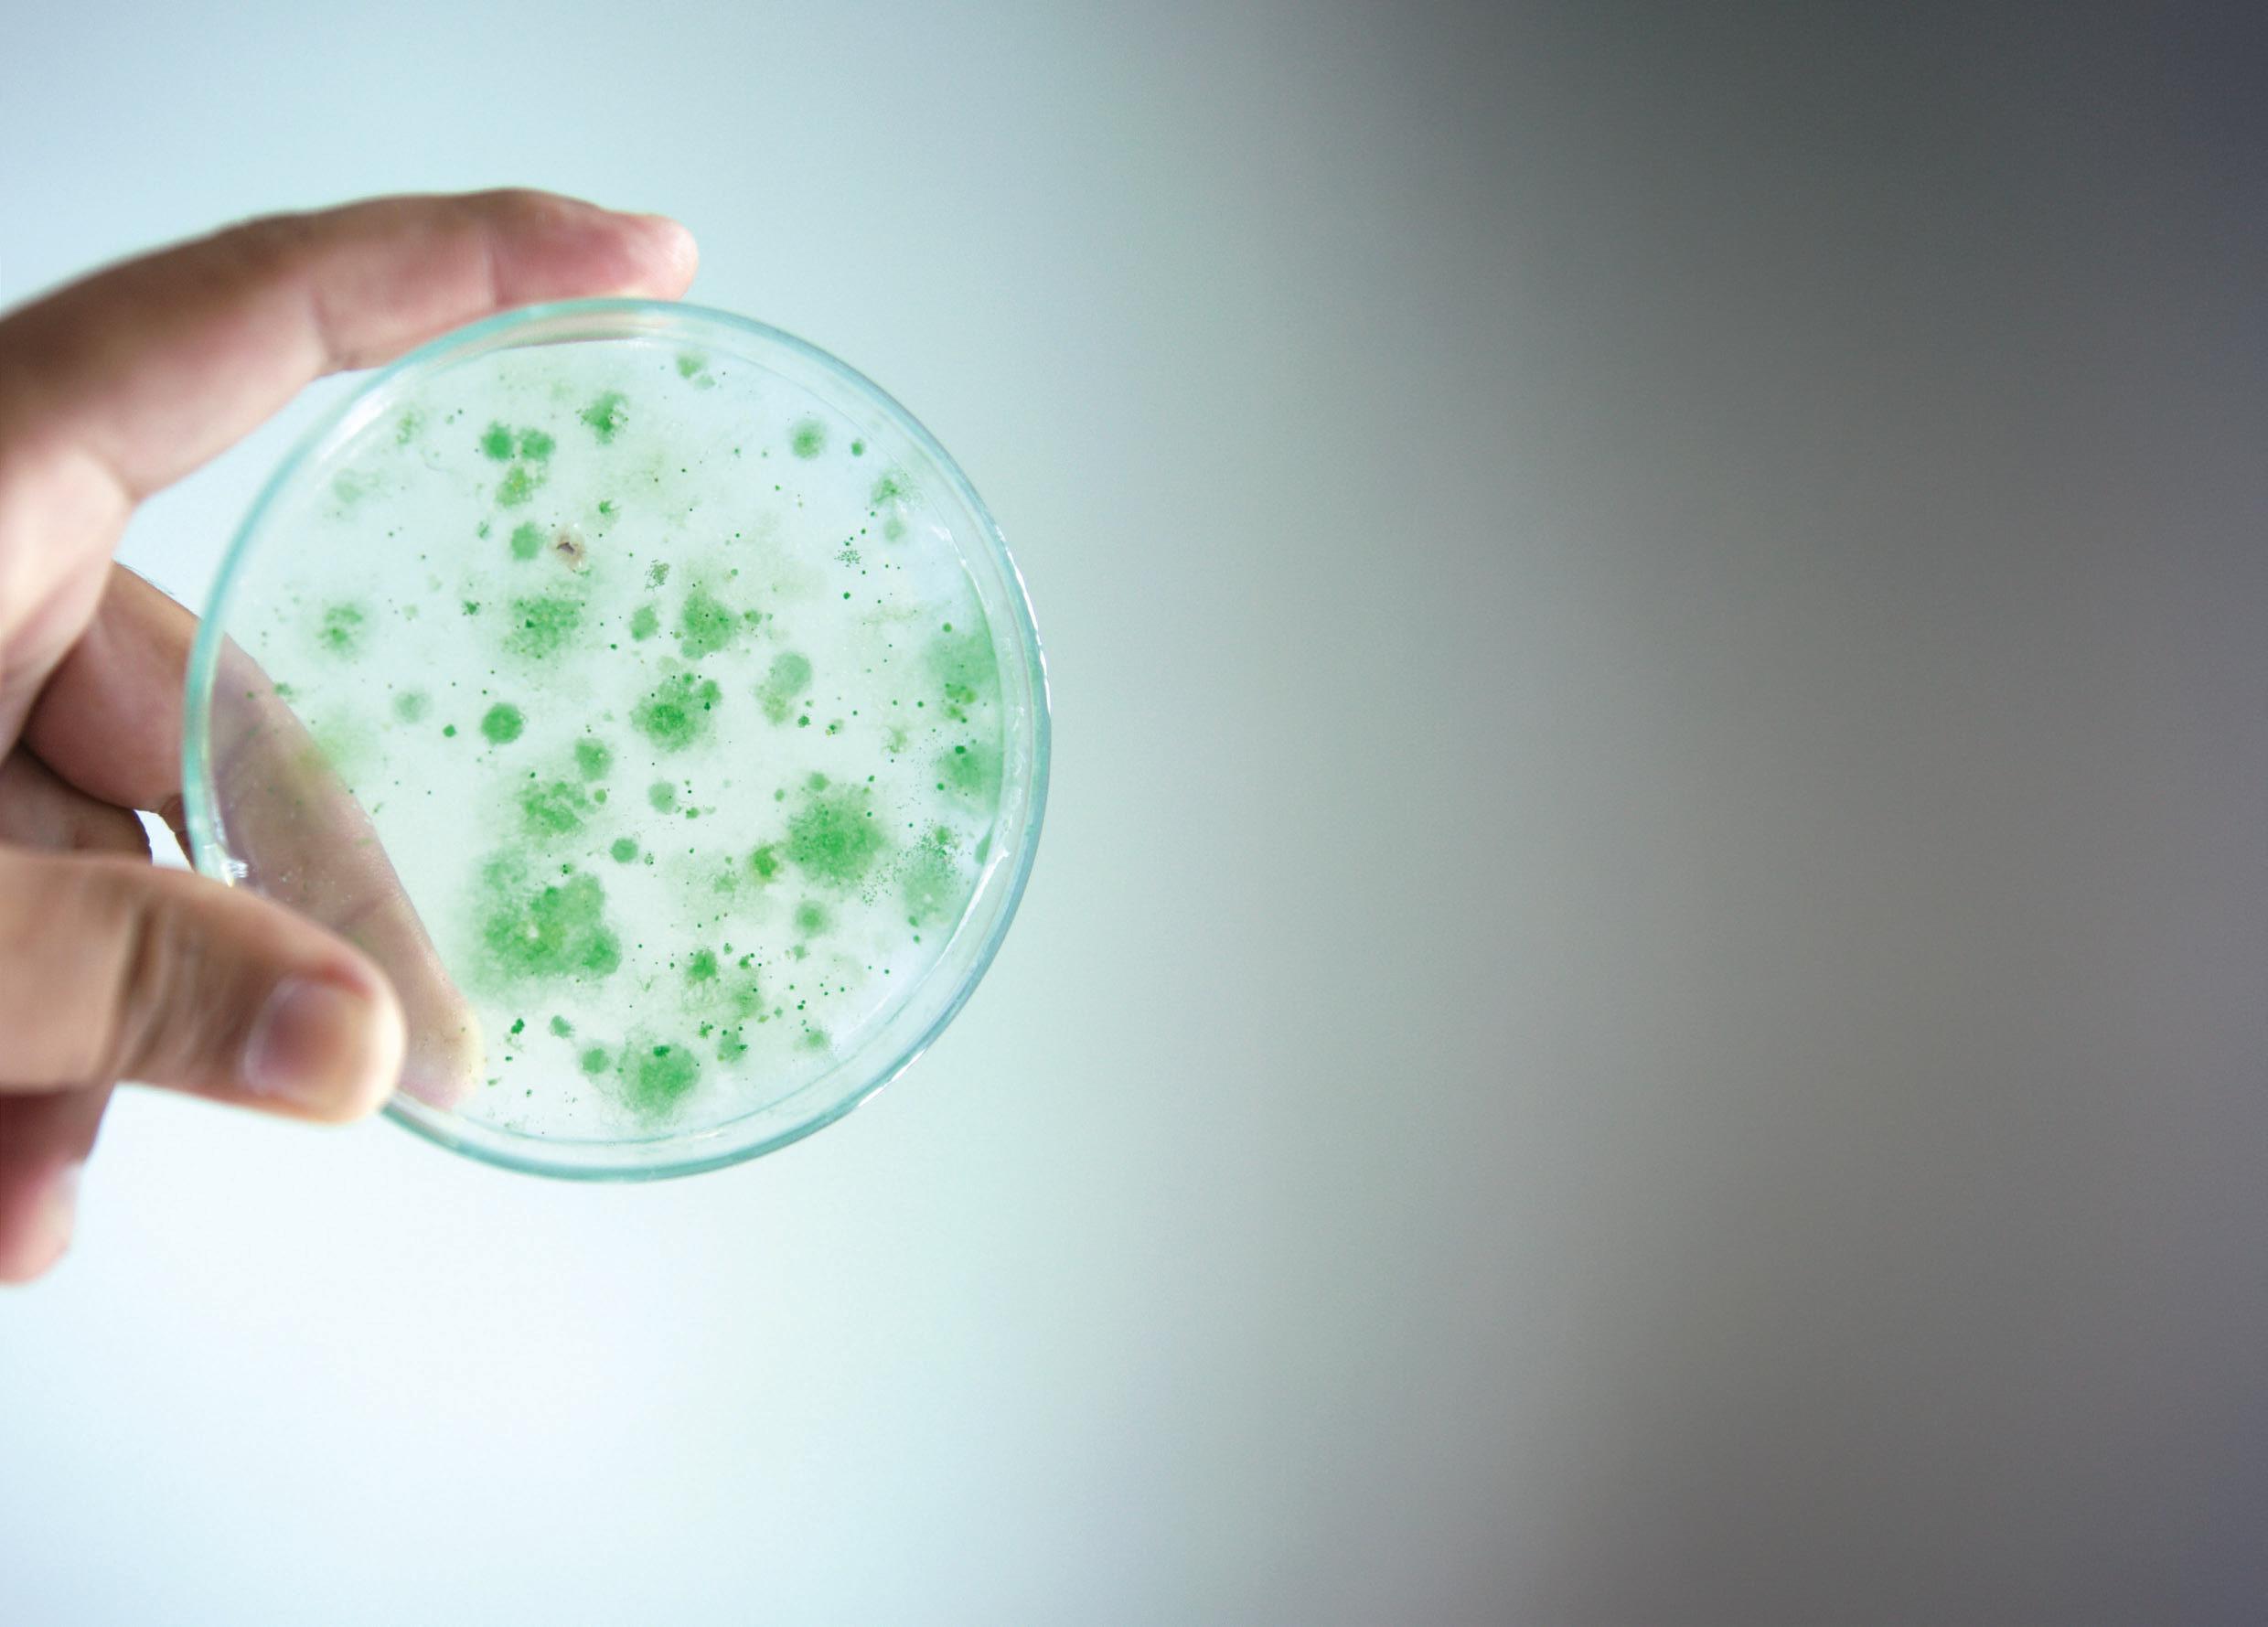
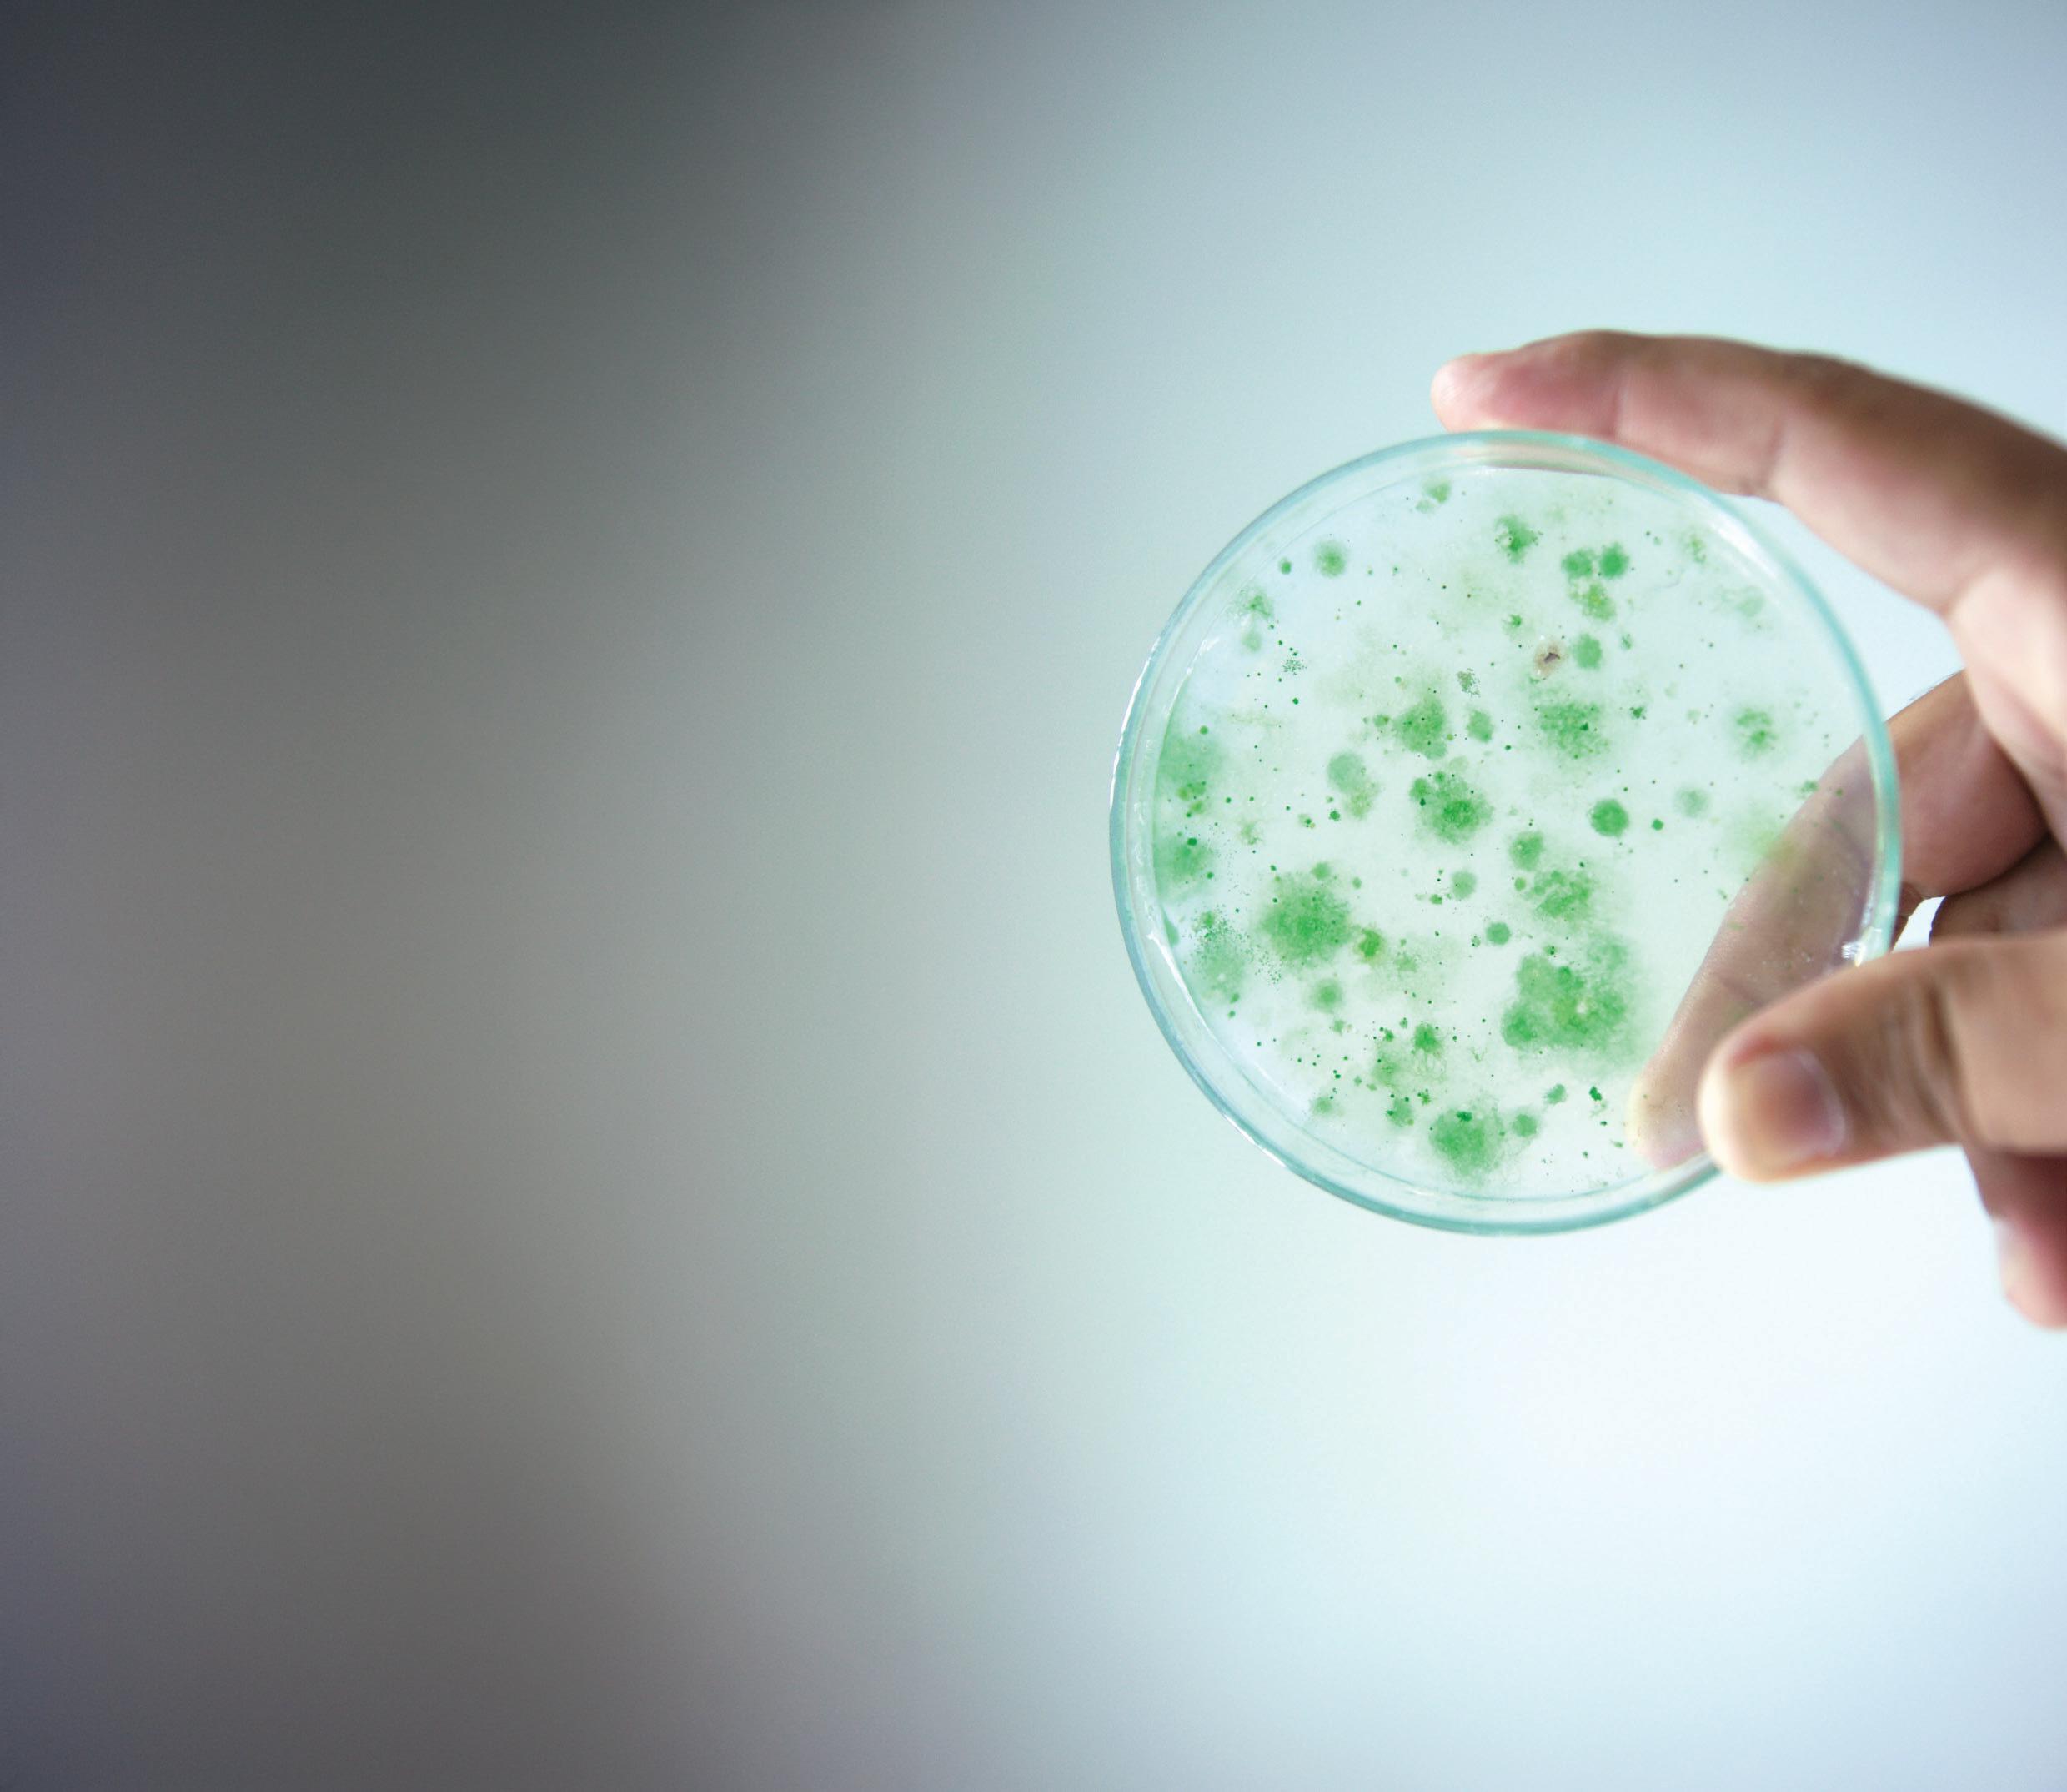

CL ARIFIER
























In all that we do, our commitment to quality is clear. From the experience of our skilled craftsmen to our command of the latest technologies, we stand apart from the competition. We take customer service very seriously, and work hard to prove it everyday.
water well services
•well cleaning and rehabilitation
•well drilling
•water treatment
•electrical and controls
•pump repair
•hydrogeological services













MICHIGAN RURAL
WATER ASSOCIATION
2127 University Park Drive, Suite 340 Okemos, MI 48864
P: 517-657-2601 www.mrwa.net
PRESIDENT
Todd Hackenberg, Village of Lawton
VICE PRESIDENT
Randy Seida, Lansing Charter Township
SECRETARY/ TREASURER
Michelle Thibideau, Village of Centreville
DIRECTORS
Tom Anthony, Village of Mattawan
Ron Bogart, City of Leslie
Andrea Schroeder, City of Davison
ASSOCIATE DIRECTORS
Cheri Laverty, Phoenix Fabricators & Erectors
Bob Masters, Peerless-Midwest, Inc.
Dale Stewart, Northern Pump and Well Company
NATIONAL DIRECTOR
Chris Kenyon, City of lonia
MRWA A DMINISTRATIVE STAFF
Tim Neumann, Executive Director
Mike Engels, Director of Training/ Assistant Director
Melisa Lincoln, Membership & Marketing Director


PUBLISHED FOR MRWA
P:

info@kelman.ca www.kelmanonline.com
MANAGING EDITOR Lauren Drew
DESIGN/ LAYOUT Tabitha Robin
MARKETING MANAGER Al Whalen
ADVERTISING COORDINATOR
Sabrina Simmonds



The Channel Monster® FLEX continues the Channel Monster legacy of high-flow capacity while capturing and shredding rags, rocks, wood, and other solids into small pieces to pass through pumps, pipes, and process equipment. The accumulation of waste debris poses significant challenges; we are committed to working hard 24/7 to enhance performance efficiency.







PRESIDENT EXECUTIVE COMMITTEE CHAIR
Todd Hackenberg, Village of Lawton
125 S Main Street
Lawton, MI 49065
Phone: 269-624-6406
Cell: 269-624-6401 hackenbergt@lawtonmi.gov
VICE PRESIDENT
Randy Seida, Lansing Charter Township
3209 W Michigan Avenue
Lansing, MI 48917
Phone: 517-485-5476
Cell: 517-819-8720 seidar@westsidewater.com


SECRETARY/TREASURER
Michelle Thibideau
Village of Centreville 221 Main Street Centreville, MI 49032
Phone: 269-467-6409
Cell: 269-506-6800 mthibideaucentreville@gmail.com
DIRECTOR
Tom Anthony, Village of Mattawan
24221 Front Avenue
Mattawan, MI 49071
Phone: 269-668-2300
Cell: 269-217-4921 tom@mattawanmi.com
DIRECTOR
Ron Bogart, City of Leslie 602 W Bellevue Street PO Box 496
Leslie, MI 49251
Phone: 517-589-8236
Cell: 517-257-3094 manager@cityofleslie.org
DIRECTOR
Daren Dood
Village of Lakeview PO Box 30
Lakeview, MI 48850
Phone: 989-352-6322
Cell: 989-289-3110 manager@villageoflakeview.org




DIRECTOR
Andrea Schroeder, City of Davison
200 E Flint Street, Suite 2
Davison, MI 48423
Phone: 810-653-2191
Cell: 810-845-1682
aschroeder@cityofdavison.org
NATIONAL DIRECTOR
Chris Kenyon, City of Ionia DPU 720 Wells Street Ionia, MI 48846
Phone: 616-523-0165
Cell: 616-813-1263
ckenyon@ci.ionia.mi.us
ASSOCIATE DIRECTOR
Cheri Laverty, Phoenix Tank
182 South Count Road 900 East Avon, IN 46123
Cell: 517-652-9906
cheri.laverty@phoenixtank.com
ASSOCIATE DIRECTOR
Bob Masters, Peerless-Midwest, Inc.
505 Apple Tree Drive Ionia, MI 48846
Phone: 616-527-0050
Cell: 616-690-8139
bob.masters@peerlessmidwest.com
ASSOCIATE DIRECTOR
Dale Stewart, Northern Pump & Well 6837 W Grand River Avenue Lansing, MI 48906
Phone: 517-322-0219
Cell: 517-242-8949
dstewart@northernpumppwco.com
EXECUTIVE DIRECTOR
Tim Neumann
Michigan Rural Water Association 2127 University Park Drive, Suite 340 Okemos MI 48864
Cell: 616-401-5436
tneumann@mrwa.net



Todd Hackenberg, President, Michigan Rural Water Association
In today’s connected world, water and wastewater systems are no longer protected by fences and locked doors alone. Much of the infrastructure that keeps our water clean and flowing – pumps, valves, treatment controls – is now managed by computers and remote technology. This brings big benefits, but it also comes with new risks Cyberattacks on public infrastructure are on the rise across the country. For water and wastewater utilities, a successful attack could mean:
• Loss of control over critical systems
• Contamination risks
• Service disruptions
• Expensive recovery efforts
• Small and rural utilities may seem like unlikely targets, but they are just as vulnerable – and often have fewer resources to respond quickly.
• Keep software and systems updated
• Use strong passwords and change them regularly
• Limit remote access and monitor system logs
• Train staff to recognize phishing emails and suspicious activity

• Have a response plan in place for cyber emergencies
Local utilities are working with organizations like the EPA, CISA, and the Michigan Rural Water Association to strengthen cybersecurity practices and stay ahead of threats. With proper training and planning, we can protect both our infrastructure and our residents.
Cybersecurity isn’t just an IT issue – it’s a public safety priority. By staying alert and investing in protection, we help ensure safe, reliable water service for our communities.








MRWA OFFICE
2127 University Park Drive
Suite 340
Okemos, MI 48864
Phone: 517-657-2601 www.mrwa.net
EXECUTIVE DIRECTOR
Tim Neumann Cell: 616-401-5436
tneumann@mrwa.net


DIRECTOR OF TRAINING/ ASSISTANT DIRECTOR
Mike Engles Cell: 231-878-3285 mengles@mrwa.net

FINANCE DIRECTOR Vacant



MEMBERSHIP/MARKETING DIRECTOR
Melisa Lincoln membersvcs@mrwa.net


COMMUNITY WATER AND WASTEWATER SPECIALIST
Kyle Bond Cell 989-745-4405 kbond@mrwa.net

WATER CIRCUIT RIDER
John Monsees Cell: 989-529-1342 jmonsees@mrwa.net

WATER CIRCUIT RIDER
Jonathan Edwards Cell: 231-429-3289 jedwards@mrwa.net
WATER CIRCUIT RIDER
John Holland Cell: 989-506-0439 jholland@mrwa.net
EPA TRAINING SPECIALIST
Joe VanDommelen Cell: 517-525-4553 jvandomnmnelen@mrwa.net
SOURCE WATER PROTECTION SPECIALIST
Kelly Hon Cell: 989-621-2361
WASTEWATER TECHNICIAN
Matt Lumbert Cell: 269-908-3792 mlumbert@mrwa.net
WASTEWATER TECHNICIAN
Amanda White Cell: 616-633-4070
ENERGY EFFICIENCY TECHNICIAN
Ginger Van Conet Cell: 517-444-1321 ggrant@mrwa.net
MESSAGE FROM THE EXECUTIVE DIRECTOR
Tim Neumann, Executive Director, Michigan Rural Water Association
In rural Michigan, clean water isn’t something people take for granted – it’s something they work for. From the Thumb to the Upper Peninsula, small towns are grappling with a sobering reality: their water systems are aging fast, their populations are shrinking, and the money needed to fix it all just isn’t there.
But despite the mounting pressure, these communities remain committed. They represent what it means to be Rural Water Strong –resilient, resourceful, and determined to keep water flowing, no matter the odds.
In dozens of towns across the state, water systems built in the 1950s or earlier are still in use. Pipes installed during the Eisenhower administration are being patched together, often by understaffed public works departments. Storage tanks fall short of modern capacity requirements, and treatment facilities run on outdated technology.
The problem isn’t just the infrastructure – it’s the context. Many rural communities have lost population over the past several decades, weakening their tax base and spreading costs over fewer households. This leaves small systems with the unenviable task of maintaining, repairing, or even replacing major infrastructure with minimal funding and limited outside support.
For many residents in rural Michigan, water bills are rising fast –sometimes double what urban residents pay for the same volume. That’s because the cost of operating and maintaining a small system doesn’t scale down. Whether it’s treating water, replacing pipes, or complying with state and federal regulations, the cost is largely fixed –no matter how many people are on the system.
This puts an outsized financial burden on working families, many of whom are already living on tight margins. And it creates a difficult balancing act for local leaders, who must decide whether to raise rates, delay maintenance, or seek outside funding that’s often limited and highly competitive.
State and federal programs offer grants and low-interest loans for water infrastructure upgrades, but the need in Michigan far outweighs the available funding. Hundreds of rural communities have applied for support, only to find themselves on long waiting lists or forced to scale back critical projects.
In response, some towns are turning to regional partnerships, asset management planning, and technical assistance programs from our staff at Michigan Rural Water Association. These efforts help stretch limited resources and give communities a roadmap for prioritizing repairs – but they can’t make up for decades of underinvestment.

Despite the challenges, rural Michigan continues to stand strong. Local public works employees show up day after day to monitor wells, repair leaks, and ensure compliance. Town councils grapple with tough financial decisions, often with little recognition. Residents continue to pay their bills, attend meetings, and ask the right questions – because they understand just how much is at stake.
Water systems might not grab headlines, but they are the backbone of public health and economic stability. In small communities, they’re the difference between growth and decline, between safety and risk.
TO PROTECT AND EXPAND PROGRAMS LIKE WEP, SUPPORTERS CAN BACK THE NATIONAL RURAL WATER ASSOCIATION’S (NRWA) RURAL WATER STRONG INITIATIVE BY ADVOCATING
FOR RURAL WATER FUNDING, CONTACTING LEGISLATORS, AND SPREADING AWARENESS OF HOW ESSENTIAL THESE SERVICES ARE TO THE FUTURE OF RURAL AMERICA.
As Michigan looks toward the future, investing in rural water infrastructure is not just a necessity – it’s an opportunity. With the right support, these communities can modernize systems, reduce costs, and protect water quality for the long term.
Being Rural Water Strong means more than just keeping the pipes working. It means preserving the places that define the state’s identity –its small towns, farms, and rural landscapes. These communities may be small, but their role in Michigan’s future is anything but.
One of the most important tools for rural communities is the USDA Rural Development Water and Environmental Programs (WEP), which provides critical funding to help small towns upgrade water and wastewater systems. These grants and low-interest loans allow rural utilities to make urgent improvements while keeping rates affordable.
To protect and expand programs like WEP, supporters can back the National Rural Water Association’s (NRWA) Rural Water Strong initiative by advocating for rural water funding, contacting legislators, and spreading awareness of how essential these services are to the future of rural America.
What can you do to help? Please take the Rural Water Strong Pledge that NRWA and the State Rural Water Associations encourage you to sign, and even submit a video stating how Rural Development keeps Rural Water Strong. Please visit the website www.ruralwaterstrong.org.

March 18–21, 2025 • Grand Traverse Resort, Acme, MI

WOMEN IN WATER AND WASTEWATER LUNCH
Miss Michigan 2024, Jenae Lodewyk, spoke about Women in the Workplace: Advocating for Women in Male-Dominated Industries.
Sponsored by Haviland


EUCHRE
Thank you to Robin Stewart from Northern Pump & Well and Darlene Devereaux from Haviland for organizing and running the tournament.
Euchre Winners
• Highest Score: Jeff Gier, Hillsdale BPU
• Most Lone Hands: Trent McNutt, Tnemec Company
Sponsored by Core and Main and Northern Pump & Well





Thank you to all the teams that participated to make this a great event. Team Bond were the winners this year – congratulations to Kyle Bond (MRWA), Jon Chopp (St. Clair Township), and Alex Pummill (Fredrickson Supply)!


• 1st Place: City of Manton
• 2nd Place: Village of Lowell

Thank you to the following exhibitors for donating a variety of spectacular prizes for MRWA to raffle off, including tree stands, coolers, knives, sweatshirts, fishing gear and more.
Donors:
• Brenntag
• Dixon Engineering
• Fleis & VandenBrink
• mTech
• Northern Pump
• Sherwin Williams

MRWA SCHOLARSHIPS
Thank you to Corey Davis of Island City Cornhole for providing the cornhole boards and running the tournament.
Cornhole Winners: 1st Place:
• Jerrett Loomis, Village of Muir
• Jon Chopp, St. Clair Township 2nd Place:
• Jason Laney, Clearbrooke Technologies
• Rob Gruener, City of New Baltimore 3rd Place:
• Todd Thibideau
• Joe Ciurlino, Solberg & Knowles
Sponsored by Kennedy Industries and Island City Cornhole



The MRWA Scholarships are available to senior students whose parents’ employer is a member of MRWA. MRWA presents two $2,000 scholarships. Congratulations to the 2025 MRWA Scholarship recipients Reid Hiltunen and Callie Faber!
The MRWA sponsors a video contest for Michigan High School Students. The goal is to create public awareness on the topics of Water Conservation or Watershed Protection. Each team is encouraged to include their local water and/or wastewater utility in their video. The grand prize of $1,500.00 is awarded to the sponsoring teacher/ department as well as $250.00 to each student of the winning team.
Rockford High School
• Aliya
• Asa
• Teagan
• Teacher: Kris Deyoung


WATER UTILITY OF THE YEAR • Zeeland Board of Public Works

EMERGING PROFESSIONAL WATER • Truman Jones, Grant Township

EMERGING PROFESSIONAL WASTEWATER • Jerry Rinehart, City of Bronson

WASTEWATER OPERATIONS SPECIALIST • Elizabeth Wilk, Nottawaseppi Huron Band of the Potawatomi

ENVIRONMENTAL PROTECTION • City of Allegan

WASTEWATER UTILITY OF THE YEAR • Village of Tekonsha

WATER OPERATIONS SPECIALIST • Scott Haltiner, City of Mt. Pleasant

MRWA PERSON OF THE YEAR • Rick Judkins, Ann Arbor Township
MRWA ROLLY OLNEY AWARD • The Rolly Olney Lifetime Achievement Award is a special award that we are proud to present to someone for their dedication and achievement in the water and wastewater industry and it is a very special award to all of us here at MRWA.
The 2025 Winner of the Rolly Olney Lifetime Achievement Award is Bob Tervonen, City of Ironwood


THE

•




PLATINUM SPONSORS


GOLD SPONSORS








SPONSORS








SPONSORS




There’s been a lot of confusion lately about when drinking water reports are due – and for good reason. Along with the report’s retention requirements and what is required in these reports. The rules come from different sections of the Michigan Safe Drinking Water Act (Act 399) and the EGLE Administrative Code, and they aren’t always intuitive. This guide clarifies key deadlines and legal references, so your water system stays compliant and organized. I will list the reports and a brief description of the report. Then I will include the wording from the Act 399/EGLE Administrative Code.
Also known as the Annual Water Quality Report, the Consumer Confidence Report (CCR) is a cornerstone of public transparency and a critical requirement for all community water supplies under both federal and state law.
The CCR informs consumers about their drinking water, including:
By John Monsees
• Where it comes from
• What contaminants were detected (if any)
• How the water compares to healthbased standards
• Educational language regarding potential health effects
• Key contacts for questions or concerns
Legal Foundation: The CCR requirement was added to Michigan’s Act 399 in 1998 and is detailed in EGLE Administrative Rules R 325.10411 to R 325.10415, in alignment with U.S. EPA standards.
• All community water supplies (Type I systems) are required to prepare and deliver a CCR every year.
• This includes both municipal systems and privately-owned community water supplies.
• Detected Contaminants: Concentrations of regulated contaminants, compared to MCLs (Maximum Contaminant Levels)
• Source Water Information: Type (e.g., surface water, groundwater) and source name
• Violations & Exceedances: Any violations of monitoring or reporting requirements, and health advisories if applicable
• Lead and Copper Results: Include the 90th percentile values and the number of homes exceeding the Action Level
• Required Language: EGLE-mandated health effects language for specific contaminants
• Public Participation Opportunities
• System Contact Information
Due Dates & Distribution Requirements:
To Consumers:
• July 1 – all community water systems must distribute the CCR to customers by July 1 each year.
• Note: “Distribution” means either mailing, direct delivery, or electronic delivery (with prior customer consent). Posting the report online alone is not sufficient unless notice is also provided.
To Purchasers (if applicable):
• April 1 – if your system sells water to another community water supply, you must send applicable CCR information by April 1, unless another date is agreed upon in a written contract.
To EGLE and Health Departments:
• July 1 – a copy of the CCR must also be submitted to:
• EGLE (usually via MiEHDWIS or email)
• local health departments with jurisdiction in your service area
Retention Requirement Period:
• Systems must keep copies of each CCR for at least three years, as stated in R 325.10415(8).
Preparation Tips:
• Use the EPA/EGLE CCR Template –it includes all the required fields and formatting.
• Double-check data against lab results and MORs to ensure accuracy and consistency.
• Have a second person proofread the report for clarity and technical accuracy.
• Providing the report in plain language –the average resident should be able to understand it.
2. CCR CERTIFICATION OF DISTRIBUTION:
This certifies that the CCR was distributed, and the data is accurate and consistent with previously submitted compliance information.
Due Date:
October 1 – must be submitted within three months of the CCR distribution date.
Important Update: This requirement is expected to be updated under the new Lead
and Copper Rule Improvements (LCRI) from the U.S. EPA. Stay tuned for changes.
• Legal Reference: R 325.10415(3)
Why the CCR Matters:
• Promotes transparency and public trust
• Educates the public about the safety and quality of their drinking water
• Encourages informed participation in local water decisions
• Demonstrates regulatory compliance to state and federal oversight agencies
Summary of CCR Requirements:
• Deliver to customers:
• July 1
• Deliver source info to purchasing systems (if applicable):
• April 1
• Submit copy to EGLE & local health department:
• July 1
• Retain report copies:
• 3 years minimum
3. MONTHLY OPERATING REPORT (MOR):
The Monthly Operating Report (MOR) is a foundational requirement for any community or noncommunity public water supply system that uses treatment affecting public health, such as disinfection, filtration, chemical addition, or corrosion control. This report serves as a detailed log of daily operations and treatment performance.
OK here is a big report topic, Monthly Operating Report/ MOR. I will support the due date by wording from the Administrative Code. The MOR is due by the last date of the following month. I understand that is confusing, for many years I thought the MOR was due by the 10th of the following month.
Who Must Submit an MOR?
Per R 325.11502, submission is required from:
• All Type I Community Water Supplies using treatment.
• Noncommunity Water Supplies employing treatment that affects public health.
• Supplies with treatment involving chemical injection (e.g., chlorine, phosphate, pH adjustment).
What Information is Included in the MOR Records?
• Daily water production totals
• Chemical dosages (chlorine, phosphate, etc.)
• Water quality parameters (turbidity, pH, temperature)
• Filter performance and run times
• Chlorine residuals
• Fluoride levels (if applicable)
• Entry point and distribution system data
Each MOR must:
• Be completed using the current EGLE-provided template
• Include complete and accurate data
• Be certified by the operator in charge
Due Dates:
• The last day of the month following the reporting month
• Example: The MOR for July must be submitted by August 31
Best Practices:
• Enter data daily, not just at the end of the month.
• Ensure staff are trained to correctly record values and read meters or analyzers.
• Regularly review the MOR before submission to catch transcription or calculation errors.
• Retain copies of MORs as part of your system’s compliance recordkeeping.
• Use MiEHDWIS or the approved submission method for your region.
Legal References: R 325.11502 – “The operation report shall be submitted to the department during the month following the month for which the operation report was prepared, unless otherwise required...”
Why It Matters? Submitting accurate, timely MORs is more than a bureaucratic task. These reports:
• Demonstrate system performance and operational reliability
• Support compliance with federal and state drinking water regulations
• Provide early warning signs of water quality or infrastructure issues
• Are used by EGLE to track system health and target technical assistance
Retention Requirement Summary:
Report Type:
• Monthly Operating Reports (MORs):
• 5 years
• Supporting Data (lab results, logs, etc.):
• 5 years
• Violation Notices/Corrections:
• 10 years (if applicable)
Based On:
• Michigan Administrative Code R 325.11502 and R 325.11504
• Federal EPA requirements under the Safe Drinking Water Act
• EGLE compliance guidance for all community water supplies
Required to Keep:
• Copies of submitted Monthly Operating Reports
• Daily logs of:
• Chemical dosages (chlorine, phosphate, etc.)
• Flow rates, pumpage, and tank levels
• Turbidity (if applicable)
• Fluoride and residual disinfectant levels
• Calibration records
• Lab data that supports MOR entries
• Corrective actions, if any values exceeded limits
• Enables EGLE audits or re-evaluations of system performance
• Required for sanitary surveys every three to five years
• Helps in identifying trends or recurring treatment issues
• Used in grant applications and capital improvement planning
• Important for legal compliance and documentation
4. BACTERIOLOGICAL & DISINFECTANT RESIDUAL SAMPLING:
Routine bacteriological monitoring is essential for ensuring that drinking water is safe from microbial contamination. In addition, disinfectant residual levels –such as chlorine or chloramines – must be monitored alongside bacteriological samples to confirm the water remains adequately disinfected throughout the distribution system.
Due Date:
• Sampling results are due by the 10th of the following month.
• Example: Samples collected in July must be submitted by August 10.
Sampling Requirements:
• You must collect bacteriological samples each month according to your approved sampling plan.
• Disinfectant residuals (e.g., chlorine levels) must be measured at the same time and place as total coliform samples.
• These results provide a dual-check:
• ensuring microbial safety while verifying disinfectant effectiveness.
• Sampling must follow the requirements outlined in:
• R 325.10704 to R 325.10709 (pre-2016 rules)
• R 325.10704d to R 325.10704h (post-April 1, 2016 rules)
Submission:
• Submit results through MiEHDWIS or directly to EGLE (based on your system’s protocol).
• Keep internal records for reference and historical compliance tracking.
No Reduced Monitoring Allowed:
• Disinfectant residual sampling cannot be reduced – it must occur every time you collect total coliform samples, regardless of your system’s size or past performance.
Retention Requirement Summary:
• Bacteriological Sampling Results (e.g., Total Coliform):
• 5 years
• Disinfectant Residual Monitoring Results:
• 5 years
• Sanitary Survey Reports, Level 1/2 Assessments:
• 5-10 years depending on findings
• Violation Records/Notices/Public Notifications:
• 10 years (minimum)
These standards align with:
• Michigan Administrative Rules: R 325.10704 through R 325.10709 (Total Coliform Rule)
• R 325.10710c and R 325.10720 for disinfectant monitoring
• EPA’s Revised Total Coliform Rule (RTCR) and Surface Water Treatment Rule (SWTR)
Specific Guidance:
• R 325.10710c(1)(a) requires systems to retain:
• “Records of microbiological analyses and any other tests required by this rule for not less than five years.”
• R 325.10710c(1)(c) adds:
• “Records of any corrective action, public notification, or Level 1/2 assessments for not less than 10 years.”
You Must Keep:
• Lab reports of total coliform and E. coli sample results
• Disinfectant residual data (e.g., free/ total chlorine) collected at time of bacteriological sampling
• Chain-of-custody forms
• Field logs and sampling location maps
• Corrective actions and public notifications
• Copies of Level 1 or 2 assessment reports and follow-ups
(SLRR)
Annual Service Line Replacement Report, new report required by EGLE. I really had to dig in the Administrative Code Starting with R 325.10604f(5)(f)(iii) and reading to R 325.10710c(5).
As part of Michigan’s evolving efforts to protect public health and reduce lead exposure, the Annual Service Line Replacement Report (SLRR) is a mandatory submission for any community water supply system with lead service lines (LSLs) or galvanized lines requiring replacement. This report tracks the system’s progress in identifying and replacing these lines to meet the state’s aggressive goal of full lead line elimination.
The SLRR is an annual summary of:
• Lead service lines replaced in the previous calendar year
• Service line material inventories and updates
• Partial vs. full replacements
• Excavation attempts and findings
• Restoration timelines
• Any obstacles to achieving replacement targets
This data helps the Michigan Department of Environment, Great Lakes, and Energy (EGLE) evaluate community progress, enforce timelines, and provide technical or financial assistance where needed.
Regulatory Basis:
• The requirement comes from Administrative Rule R 325.11604(c)(vii), which states:
• “A supply with lead service lines shall annually provide the department a summary of service line repairs or replacements in a form and manner specified by the department.”
• Also cross-referenced with R 325.10604f(5)(f)(iii) through R 325.10710c(5), tying the service line work to Michigan’s Lead and Copper Rule (LCR) enhancements.
Due Date:
• March 31 every year
• The report must be submitted by March 31 for work completed during the previous calendar year.
• Example: For replacements done in 2024, the report is due by March 31, 2025.
How to Submit:
• Submit the completed form:
• Through MiEHDWIS (preferred)
• Or directly to your EGLE district office via email (check local guidance)
Retention Requirement Summary:
• Required Retention Period: 12 years from the date of submission or the period of operation the data covers, whichever is longer.
• This includes:
• The completed SLRR form
• All excavation records
• Material verification data
• Photos, sketches, or GPS records
• Contractor records and invoices (if applicable)
• Copies of communications with customers related to line replacements
6. ANNUAL CROSS CONNECTION CONTROL REPORT:
This long-standing report confirms the status and progress of your backflow prevention program.
This is what is printed on the Annual Cross Connection Report. Return the completed form by March 31, 2025, to the appropriate Department of Environment, Great Lakes, and Energy (EGLE) district office to comply with administrative Rule R 325.11404 that states “a water utility shall report annually to the department on the status of the cross-connection control program on a form provided by the department.”
Due Date:
• March 31 – Submit the completed EGLE form to your district office.
Legal Reference:
• R 325.11404 Local cross connection control programs:
• (4) A water supply shall report annually to the department on the status of the cross-connection control program on a form provided by the department.
Retention Requirement Summary:
• Required Retention Period: 10 years, per EGLE and federal guidance based on the Michigan Safe Drinking Water Act (Act 399) and industry best practices.
• While the exact retention time is not directly stated in Rule R 325.11404
REPORT
Consumer Confidence Report (CCR)
CCR Certification of Distribution
Monthly Operating Report (MOR)
Bacteriological/Disinfectant Results
DUE DATE
July 1 (April 1 if seller)
October 1
Last day of next month
10th of next month
Annual Service Line Replacement Report March 31
Annual Cross Connection Report
Annual Pumpage/Usage Report
(which governs cross connection control programs), the 10-year standard is applied based on the fact that:
• Cross connection program documentation is considered a key compliance and public health record
• Retention aligns with EPA’s CrossConnection Control Manual and Michigan’s drinking water program guidance
What to Keep for 10 Years:
• A copy of the submitted Annual Cross Connection Report
• Records of:
• Inspections and surveys
• Test results for backflow prevention assemblies
• Notices of violation or correction orders
• Follow-up communications
• Certified tester credentials (if applicable)
7. ANNUAL PUMPAGE/USAGE REPORT: Required for Type I systems that do not submit Monthly Operating Reports (MORs). It includes total water pumped and water usage data for the previous calendar year.
Due Date:
• March 31 – following the year being reported.
Tip: Even if not required, submitting this report annually can help support future grant applications and infrastructure planning.
Legal Reference:
• R 325.11504 Annual reports. Rule 1504. (1) A type I public water supply which does not submit a monthly operation report shall submit an annual report on a form provided by the department. The department may require certain type II public water supplies to submit annual reports. The report shall include
March 31
March 31 (if applicable)
a summary of water pumpage and water use.
• (2) The type I public water supply shall submit the annual report to the department on or before March 31 following the year covered by the report.
Retention Requirement Summary:
• Required Retention Period: Five years, based on guidance from EGLE and consistent with other water use and operational reports under Michigan’s drinking water rules.
• While Administrative Rule R 325.11504 (governing the report) does not specifically state a retention period, EGLE follows the five-year retention standard as applied to:
• Monthly operating reports (MORs)
• Pumpage and water use records
• Operational logs and summaries
Keep These Records for Five Years:
• A copy of each Annual Pumpage/Usage Report submitted
• Supporting data such as:
• Daily/weekly/monthly pump logs
• Meter readings
• Water use summaries
• Operator notes or source use logs
• Backup from SCADA or telemetry (if used)
Staying ahead of these deadlines helps your water system avoid violations and ensures public trust in your drinking water. Bookmark this guide, distribute it to your staff, and check your MiEHDWIS dashboard regularly for reminders.
Contact your EGLE District Office or visit www.michigan.gov/EGLE for forms, submission portals, and updated regulatory guidance.

REPLACED, REVIVED, READY

THE CITY OF WAYLAND, MICHIGAN, (population 4,435), was facing persistent issues at its main lift station, which conveys flow directly to the City’s lagoon system. Repeated failures and unsuccessful rebuild attempts of the existing centrifugal pumps made clear that a long-term solution was needed.
SUMMARY:
Customer: City of Wayland
Project:
Main Lift Station Pump Replacement
Equipment:
• (2) Pioneer GS Series Pumps
• Pump base and piping supports
• Associated valves and fittings
Result:
Providing a modern upgrade while avoiding the higher cost of extensive repairs or structural changes.


The existing pumps had become unreliable, leading to frequent call-ins and rising maintenance costs. Despite multiple repair attempts, performance remained inconsistent. Safety concerns and excessive downtime placed pressure on city resources. With a tight layout and aging infrastructure, a straightforward repair or retrofit wasn’t feasible.
After evaluating repair options, the City found that replacing two of the three pumps would be more cost-effective than continuing to maintain aging equipment. The original station layout and piping configuration required a direct-fit solution to minimize construction changes and reduce downtime.
(continued on the next page)




The City partnered with Kennedy Industries to evaluate options and restore reliability at the main lift station. After a thorough site review, Kennedy delivered a turnkey solution that included:
• Recommended direct replacement using (2) Pioneer GS pumps
• Seamless integration with the existing piping layout to minimize modifications
• Removal of aging pumps and stabilization of existing piping infrastructure
• Full commissioning support, ensuring a smooth return to operation
• Cost-effective implementation, reducing downtime and long-term maintenance needs
This approach provided a modern upgrade while avoiding the higher cost of extensive repairs or structural changes.
The City of Wayland now benefits from a significantly more reliable and lowmaintenance lift station, reducing the burden on city personnel and resources. With efficient equipment and seamless integration into the existing infrastructure, the station operates with improved consistency and fewer unplanned interruptions. Supported by Kennedy Industries’ comprehensive implementation and startup services, the upgrade has positioned the City for long-term operational stability and cost savings.
With modern, efficient pumps and a streamlined installation, the City of Wayland now benefits from a more reliable, low-maintenance lift station—ensuring consistent service and long-term value for the community.

From our humble beginnings in Jackson over 20 years ago to nine locations spanning the entire state of Michigan, Michigan Pipe & Valve is dedicated to supplying residential, commercial and municipal clients alike with top quality products and customer service. Find the location nearest you and reach out to us so that we can help you fulfill your needs, large or small .
Gaylord
375 Chestnut St, Gaylord, MI 49734 (989) 889-6682
Genessee 1217 E. Stanley Rd. Mt. Morris, MI 48458 (810) 547-7154
Grand Rapids 5500 36th St SE Grand Rapids, MI 49512 (616) 805-3206
Holland 518 E.16th Holland, MI 49423 (616) 376-8636
Jackson 3604 Page Ave Jackson, MI 49203 (517) 764-9151
Kalamazoo 3308 Covington Rd Suite C Kalamazoo, MI 49001
Mt. Pleasant 1314 S. Mission Road Mt. Pleasant, MI 48858 (989) 817-4331
Saginaw 596 Kochville Rd. Saginaw, MI 48604 (989) 752-7911
Traverse City 487 West Welch Court Traverse City, MI 49686 (231) 929-7473
DUCTILE IRON PIPE
VALVES, HYDRANTS
WATER METERING
HDPE PIPE, PVC PIPE AND FIITINGS
TOOLS AND MUCH MORE

Perfluoroalkyl and polyfluoroalkyl substances, or PFAS are a diverse group of synthetic organofluorine compounds characterized by strong bonds between fluorine and carbon atoms. They are characterized by having multiple fluorine atoms attached to an alkyl chain. Alkyl chains consist of hydrogen and carbon atoms arranged in a tree-like structure having the general formula CnH2n+2. Typically, this fluoridated carbon chain is eight carbon atoms long. The simplest alkyl chain is methane gas, which is sometimes called the parent molecule for the alkane group. Both propane and butane are also members of this chemical group. Additionally, to manufacture different PFAS compounds, chemists can change atoms on the alkyl groups. Currently the USEPA list 14,735 different PFAS compounds, however, some chemists have estimated that there could be as many a 7 million.
The first PFAS compound invented was polytetrafluoroethylene (PTFE) or Teflon by the



Dupont Company in 1938. Teflon is chemically inert and has one of the lowest friction coefficients of any compounds making it useful in a wide variety of applications.
Most PFAS compounds are fluorosurfactants or fluorinated surfactants, making them both lipophobic (lipo = fat, phobic = repelling) and/or hydrophobic (hydro = water). Surfactants are chemical compounds that decrease the surface tension between two liquids. This subgroup of PFAS compounds have a hydrophobic fluorinated “tail” and hydrophilic (philic = loving) “head”. This unique chemistry allows the PFAS compounds to be extremely effective surfactants for both water and grease. Perfluorooctanoic acid (PFOA) (Figure 2) is an example of a surfactant compound used in floor waxes, wax paper, and some firefighting foam.
In order to create different compounds with differing properties, chemists simply change the “head” end of the basic “tail” end of the compound. You can see how chemists have changed the basic “tail” structure by comparing PFOA (Figure 2) and PFOS (Figure 3). While these changes look minor, they can have a huge impact on the properties of the different compounds. For example, PFOS has a boiling point of 271°F (133°C) and PFOA has a boiling point of 378°F (192°C). Another example is PTFE (Teflon) has a melting point of 621°F (327°C) compared to PFOA’s melting point of 122°F (50°C).
By John Holland, Water Circuit Rider


In general, both the hydrophobic and lipophobic properties of the PFAS compounds have made them extremely useful in a huge range of products. They have been used in lipstick, food wrappers, fire fighting foams, pump packing, cookware, shampoo, carpets, waterproof fabrics, nail polish, lip balm, eye liner, paint, furniture, paper treatment and any number of other commercial and industrial products. A recent study by the University of Florida on toilet paper found the in everyone of the 21 name brands tested PFAS was found in them. The prevalence of these compounds has become innocuous throughout our lives and the environment. We can only expect more research and regulations to follow in the upcoming years.
By Amanda White, Wastewater Technician
Every spring, one of the most common questions asked by Wastewater Operators is, “How do I get rid of the algae in my pond?”
Across the State of Michigan, wastewater operators are facing increasing challenges with algal overgrowth, as spring comes to an end. Whether you’re managing a mechanical plant or a stabilization lagoon, algae have the potential to create many problems with wastewater treatment. Algae can reduce system efficiency, foul equipment, trigger odor complaints and jeopardize compliance with EGLE discharge permits.
While chemical treatments and manual removal have been traditional approaches, a cleaner, low-maintenance alternative is now gaining momentum in Michigan and across the Midwest: ultrasonic radar.
Ultrasound technology was first developed for military sonar in the early 20th century and soon expanded into industrial use – like tank level monitoring. By the early 2000s, researchers discovered that specific ultrasonic frequencies could disrupt algal cells, leading to early use in lakes, reservoirs, and aquaculture.
In the last decade, advances in sensor durability, signal tuning, and SCADA integration have brought ultrasonic algae control to wastewater plants and lagoons, offering a practical tool for operators who need long term results, without added complexity.
Ultrasonic radar systems use highfrequency sound waves to both detect and control algae. Depending on the needs of the system, different options are available. The basic level suppression mode device distributes an Ultrasonic Signal, at a set pace and strength, which disrupts the growth and environment for algae. A more sophisticated system, capable of monitoring algae content and thickness, communicates with SCADA to increase/decrease ultrasonic waves based on real-time data collected from the unit.
1. Monitoring Mode
• A submerged transducer emits ultrasound pulses into the water.
BENEFIT
Non-Chemical Algae Control
• Reflected echoes from particles (like algae) are analyzed in real time.
• Operators get data on:
• Algae concentration
• Vertical distribution
• Trends over time
• Output connects to SCADA or a dedicated interface.
2. Suppression Mode
• The system emits low-power, high-frequency sound that interferes with algae:
• Gas vesicles, used to float to the surface
• Cell membranes and reproduction processes
WHY IT MATTERS IN MICHIGAN
Avoids chemical residuals in sensitive Great Lakes watersheds.
Low Labor Ideal for small-town DPWs with limited staffing.
Improves Effluent Clarity
Reduces Odors
Compatible with SCADA
Year-Round Resilience
Enhances performance of UV disinfection and nutrient polishing.
Prevents anaerobic surface mats in lagoons.
Integrates with systems used across Michigan municipalities.
Operates in ice-prone basins with durable, low-maintenance components.
IN MICHIGAN, WHERE PROTECTING WATER QUALITY AND STRETCHING OPERATIONAL BUDGETS GO HAND IN HAND, ULTRASONIC RADAR OFFERS AN IDEAL ALGAE CONTROL STRATEGY. IT ALIGNS WITH ENVIRONMENTAL GOALS, REDUCES OPERATIONAL BURDEN, AND WORKS EFFECTIVELY IN BOTH MECHANICAL AND LAGOON SYSTEMS.
• Algae lose buoyancy, sink, and degrade naturally – without killing beneficial microbes or releasing toxins.
This makes ultrasonic radar safe to use in biological nutrient removal systems, aerated & facultative lagoons, and even reuse ponds.
IS THIS RIGHT FOR YOUR SYSTEM?
• Lagoon Systems:
• Floating units which can be line or solar powered
• Sized properly to your pond to ensure correct output
• Position near inlets or highgrowth zones
• Best results when algae are just beginning to bloom
• Easily removed during cold weather or cleaning
• Mechanical Plants:
• Mount transducers in clarifiers, equalization tanks, or polishing lagoons
• Link output to SCADA or telemetry systems
CATEGORY
ULTRASONIC RADAR
• Adjust frequency bands based on local algae types
• Seasonal blooms: Warmer summers and nutrient-rich influents drive rapid algal growth, especially in facultative lagoons.
• Nutrient regulations: Tighter phosphorus and nitrogen discharge limits mean algae control is more important than ever.
• Budget constraints: Small municipalities need low-labor, long-lasting solutions that don’t require costly chemicals or overtime.
Ultrasonic radar offers a modern, sustainable algae control method that aligns with Michigan’s environmental priorities and infrastructure realities.
Though initial costs vary ($5,000–$20,000 per unit depending on coverage area and level of technology upgrades), it is estimated that a facultative lagoon facility
CHEMICAL TREATMENT
could see a return on investment in 12 to 18 months through:
• Lower chemical costs
• Reduced filter cleaning or skimming labor
• Improved effluent quality and regulatory compliance
• Permitting costs
• Risk of heavy metal build up in sludge In Michigan, where protecting water quality and stretching operational budgets go hand in hand, ultrasonic radar offers an ideal algae control strategy. It aligns with environmental goals, reduces operational burden, and works effectively in both mechanical and lagoon systems. If you’re looking for a smarter, more natural way to manage algae – without relying on chemicals or extra labor – ultrasound may be your next best investment. If you have any questions about this type of treatment, or any other please contact a Michigan Rural Water Wastewater Technician. We would be happy to assist you in finding the right solution for your unique situation.
CONTROL (SKIMMING/CLEANING)
Effectiveness High – Continuous suppression and prevention Moderate to High – Fast-acting but short-lived Low to Moderate – Labor-intensive, temporary
Mode of Action Acoustic disruption of algal cell function Chemical oxidation or toxicity
Physical removal of surface biomass
Environmental Impact Very Low – No chemicals used Moderate to High – Can affect downstream ecology Low – But can disturb settled solids
Operational Labor Very Low – Set and monitor remotely Moderate – Requires storage, dosing, monitoring High – Frequent manual labor or equipment use
Impact on Beneficial Microbes None – Targets only algae Can harm nitrifiers and other microbes Minimal
Integration with SCADA Yes – Real-time data and remote control Possible – If dosing pumps are automated
Response Time Continuous, proactive Rapid – Algae killed quickly
Maintenance Needs Low – Periodic transducer cleaning/checks Moderate – Chemical handling and pump upkeep
Capital Cost Medium to High ($5K–$20K depending on size) Low to Medium – Ongoing costs per dose
Annual Operating Cost
Scalability (Small-Large Systems) High – Works for ponds to full plants
– Due to recurring chemical purchases
– But more complex in large systems
– Manual process
– Reactive and dependent on labor
– Repeated manual effort
initial cost – High recurring labor cost
– Labor, equipment wear, safety costs
– Labor limits scalability
Best Use Case Long-term prevention in automated systems Emergency knockdown of severe blooms Small systems or temporary response
SUMMARY
Ultrasonic Radar: Best for long-term, sustainable control with minimal labor or environmental risk.
Chemical Treatment: Useful for quick response but carries ongoing costs, permitting and concerns with effects on sludge.
Manual Control: Suitable for small or temporary setups, but not scalable or cost-effective long term.

Kelly S. Hon, MRWA Source Water Protection Specialist
The City of Gladwin, located in central Gladwin County, is a small, rural community in northern Michigan. The City, previously named Cedar, received its present name in 1883 after Major Henry Gladwin. Major Gladwin was a British commander who bravely defended the fort at Detroit during the year long siege by Chief Pontiac in 1763. Gladwin was incorporated as a city in 1893. Also, the county seat, Gladwin is a mix of family-owned restaurants and shops, within a two-hour drive from most of the metropolitan areas of the state. Gladwin covers approximately 2.9 square miles and has a total population of approximately 3,069.
The City of Gladwin’s drinking water is supplied from groundwater, drawn from an underground aquifer. This water is processed through the Iron Removal Plant, operated and maintained by the Department of Public Works (DPW). The plant uses a sand filtration system to remove approximately 95% of the iron from the water. After filtration, the water is treated with chlorine and phosphate before being stored in the water tower for distribution. Both the treated drinking water and the raw well water undergo regular testing for various water quality parameters, as required by permit. The DPW ensures the upkeep of the water distribution system through activities like flushing water mains, repairing leaks, replacing old or broken water meters, and maintaining valves and fire hydrants. The City of Gladwin’s public water supply system (PWSS) serves approximately 3,069 customers.
In June of 2004, the City of Gladwin applied for a grant through the Michigan Source Water Protection Grant Program to complete a hydrogeology report. The City worked with Rowe Incorporated to conduct the study. Insight Environmental Services Incorporated was retained by Rowe Incorporated to assist in defining the Wellhead Protection Area (WHPA). The report was finalized in 2005 and summarized well installation activities along with a detailed analysis of site and area hydrogeology. In 2006, the City had samples sent to a lab and results confirmed that the City’s PWSS receives groundwater that is non-detect for tritium. Communities whose PWSS is non-detect for tritium are not required by the State of Michigan to conduct a computer-modeling delineation. Rather, a one-mile radius may be drawn around the PWSS and is referred to as the WHPA.
In 2006, the City of Gladwin began working with the Michigan Rural Water Association (MRWA) to receive assistance with the development of their Source Water Protection Program (SWPP) Plan. The SWPP Plan was approved by the Michigan Department of Environment, Great Lakes and Energy (EGLE) in May of 2007. Since 2007, the team has applied for and received grants under the Michigan Source Water Protection Grant Program. Realizing the importance of maintaining an active program, the city worked with the MRWA to complete an updated Plan in 2013 and 2019. A third update will be done over the next two years.
IN 2006, THE CITY OF GLADWIN BEGAN WORKING WITH THE MICHIGAN RURAL WATER ASSOCIATION (MRWA) TO RECEIVE ASSISTANCE WITH THE DEVELOPMENT OF THEIR SOURCE WATER PROTECTION PROGRAM (SWPP) PLAN. THE SWPP PLAN WAS APPROVED BY THE MICHIGAN DEPARTMENT OF ENVIRONMENT, GREAT LAKES AND ENERGY (EGLE) IN MAY OF 2007.

The local SWPP Committee includes a strong group of people that represent various interests in the community. Over the years, team members have included the following:
• City Mayor
• City Manager
• Superintendent of Water and Wastewater
• City Clerk
• City Treasurer
• Assessor/Zoning Administrator
• Utility Billing Clerk
• Fire Chief
• School Representatives
• MSU Extension
• Local Business Owners
• Gladwin County Emergency Manager
• Residents
• MRWA Source Water Protection Specialist In addition to being a diverse group of people, they are committed to source water protection. Team members consistently attend meetings and volunteer excellent ideas that have made the SWPP the success that it is today. Like other communities, the city has had staffing changes due to retirements and career moves. Instead of pushing the program aside, each new staff member has picked up where the previous person left off. Partnering with local and county emergency response prior to an incident is another key component for successful source water protection implementation and the City of Gladwin has done a great job in this area. Having emergency response personnel on the SWPP Committee is an important start. In addition to having the Gladwin Fire Chief as an active member since the program’s inception, in more recent years, the Gladwin County Emergency Manager has joined the SWPP Committee. The partnership between the City of Gladwin and Gladwin County Emergency Management has been important for emergency response communication barriers, preparation, planning and protocols along with contamination source identification, management and risk. The city experienced
firsthand an incident that extended across the boundaries of city and county lines and had a significant impact on source water quality and quantity. May of 2025 marks the sixth anniversary of the dam failure that caused catastrophic flooding within Midland and Gladwin counties. In and through the two agencies partnerships, specific needs for both the City of Gladwin and Gladwin County have been addressed, especially as agencies apply for grants and determine equipment and staffing needs to deal with this event and future incidents. In addition, the city has partnered with the local elementary, middle, high and after school programs to educate youth. These partnerships have been instrumental to the success and longevity of the City of Gladwin’s SWPP.
The city has implemented a fantastic education and outreach program, and they realize that environmental education is an ongoing effort. Their passion to protect is evident in the activities that they have worked on in the past and in those that they will focus on in the future.



SINCE THE SPRING OF 2018, THE CITY HAS HELD A BANNER DESIGN CONTEST. THIS ACTIVITY HAS BECOME A LOCAL FAVORITE, AND THE DOWNTOWN STREETS LOOK SO FESTIVE IN THE SUMMER LINED WITH CREATIVE ART AND FACTS ABOUT WATER.
For many years, the City has partnered with the local schools on drinking water protection efforts. Initially, Kelly Hon, MRWA Source Water Protection Specialist conducted groundwater model demonstrations and edible aqui-flurry activities with students annually. Kable Thurlow, MSU Extension Educator, also assisted. Realizing it was an important part of the curriculum, the science teacher wanted to be trained. The MRWA assisted her and provided groundwater model curriculum. Each year thereafter, the science teacher continued the groundwater model demonstrations and edible aqui-flurry activities. After realizing the benefit of educating all ages, the city purchased and donated a groundwater model to the local schools. For many years, they also annually purchased and delivered the supplies for the Aqui-flurry sessions.
Since the spring of 2018, the city has held a banner design contest. This activity has become a local favorite, and the downtown streets look so festive in the summer lined with creative art and facts about water. Initially, the city started out asking third through fifth grade students to participate and in more recent years, extended the invitation to kindergarten through senior classes. Winners are chosen, cash prizes are awarded, banners are displayed throughout the downtown area and t-shirts are made for the winners with their drawings on them. A press release is also done and printed in the newspaper and posted on social media. The event has been successful, receiving positive feedback from the community. Consequently, the contest continues annually.
The city also works with the Gladwin High School staff to organize field trips to the wastewater treatment plant, lagoons, water tower and Iron Removal Plant. In addition, the city learned that Gladwin High School had a
refillable water station. Consequently, they purchased reusable water bottles with the slogan “Gladwin: Committed to Protecting Your Drinking Water”. The city distributed the bottles to all high school students. They would also like to work with the other schools to see if they currently have or are interested in installing refill stations. If refill stations are not available, they would like to encourage their installation and if they are installed, the city will purchase and distribute reusable water bottles to students.
While the city is educating students, they are also targeting residents. In addition to the banners that have educational messages on protecting source water, the city also purchased and installed drinking water protection road and trail signage. They have also passed out a variety of items at local events such as coloring books, leak
detection tablets and rulers. The city received placemats, brochures and an article series on drinking water protection from the MRWA Source Water Protection (SWP) Specialist. Placemats have been given to local restaurants within the city and brochures were placed at City Hall.
The article series ranges in topics from an overview of the WHPP, proper maintenance of septic systems, recycling and household hazardous waste collection to storm water management, water conservation and proper disposal of pharmaceuticals. The city places these articles in their summer and winter newsletters. In addition, they would like to put them on their social media page.
Household hazardous waste includes products that consumers purchase and use every day in their homes that can harm the environment if not handled and stored properly. Disposing of these products is an


important piece of protecting our source water. Since 2008, the city has held an annual household hazardous waste collection day. The collection day has been advertised each year and has been a huge success. In 2018, for example, the city collected 5,753 pounds of electronics along with a variety of other items. The city has worked diligently to continue hosting this annual event, which has proved difficult in more recent years as prices for disposal of hazardous items have increased and the market for disposal companies to hire has decreased. Finding ways to get creative through local partnerships has been a more recent focus for City staff.
The City of Gladwin has done a fantastic job understanding the importance of managing the land within their community and recognizing that local units of government are responsible for the management of the land within their jurisdiction. Consequently, and since the SWPP Plan Update in 2007, the city has implemented several management strategies for drinking water protection. The city reviewed their current zoning ordinance and site plan review criteria, and they incorporated groundwater/ wellhead protection standards along with a map of the Wellhead Protection Area (WHPA). The city also revised their Master Plan and included information about their SWPP goals, objectives and WHPA map. The city conducted a search of abandoned wells in 2010-2011. One very deep well that was a significant threat to the City’s aquifer (because of depth and location) was plugged, and the city plans to plug other abandoned wells. They also placed information in the local newspaper with the hope of continuing to educate the public about the dangers of abandoned wells.
The City will continue to implement the site plan review standards and zoning ordinance. Other management approaches that the City of Gladwin has either implemented or plans to utilize in the future are described below.
The City’s WHPA includes four adjacent Townships. The city would like to work with these Townships to develop an intergovernmental agreement for groundwater protection. First, the city is interested in educating them about the local SWPP. By doing so, they hope that they will understand

the importance of protection measures. The City is concerned primarily with commercial development in these Townships. Consequently, they would like to see the Townships adopt the Environmental Permits Checklist and site plan review standards that include groundwater protection measures. Prior to receiving a building permit, the Township and City would need to approve the plan. The city is in the process of incorporating the Environmental Permits Checklist into their current site plan review standards.
• Local MSU Extension staff educate farmers about programs such as:
• Farm*A*Syst
• Crop*A*Syst
• Michigan Emergency Tube
• Michigan Clean Sweep
Kable Thurlow, MSU Extension staff member has been on the committee since its inception. They send quarterly newsletters to farmers and pass information out at various events. Kable has also done a terrific job in terms of partnering with the City and the MRWA on educational efforts for source water protection within the local schools.
Because the WHPA is primarily residential, the City has worked to educate homeowners within the WHPA. The City has sent information in quarterly newsletter to residents. MSU Extension staff also work with homeowners through the Home*A*Syst program. This program helps homeowners learn what daily practices harm and help the environment.
BECAUSE THE WHPA IS PRIMARILY RESIDENTIAL, THE CITY HAS WORKED TO EDUCATE HOMEOWNERS WITHIN THE WHPA. THE CITY HAS SENT INFORMATION IN QUARTERLY NEWSLETTER TO RESIDENTS. MSU EXTENSION STAFF ALSO WORK WITH HOMEOWNERS THROUGH THE HOME*A*SYST PROGRAM. THIS PROGRAM HELPS HOMEOWNERS LEARN WHAT DAILY PRACTICES HARM AND HELP THE ENVIRONMENT.
As is evident by the educational examples, management approaches and emergency response planning coordination, the City of Gladwin has implemented a successful drinking water protection program. Team members have been engaged and committed since the program’s inception and recognize the importance of making the SWPP a priority. Management approaches have been implemented to ensure a better protected public water supply system. Strong partnerships have been formed between the various City Departments (Utilities Department, Planning Department, Water Department and Fire Department) and other organizations. The coordination of efforts between Gladwin Public Schools, MSU Extension, Gladwin County Emergency Management and the City has played an extremely vital role in the program success. The Gladwin SWPP has been a great illustration, demonstrating the importance of working together with persistence to protect our most valuable resource. In 2019, their efforts did not go unnoticed as they received the MRWA Exemplary Efforts in Environmental Protection Award.
The city should be proud that over the last twenty-one years, they have worked diligently to safeguard their drinking water supply system. They realized that the term “SWPP” does not mean developing a report that sits on a shelf. Rather, a SWPP is intended to be updated, evaluated and implemented. It requires proactive planning and the development

THE CITY SHOULD BE PROUD THAT OVER THE LAST TWENTY-ONE YEARS, THEY HAVE WORKED DILIGENTLY TO SAFEGUARD THEIR DRINKING WATER SUPPLY SYSTEM. THEY REALIZED THAT THE TERM
“SWPP”
DOES NOT MEAN DEVELOPING A REPORT THAT SITS ON A SHELF. RATHER, A SWPP IS INTENDED TO BE
UPDATED, EVALUATED AND IMPLEMENTED.
and implementation of public education activities that fit within the community. It requires strong partnerships that lead to difficult conversations and effective courses of action. The City of Gladwin believes in the value and purpose of the source
water protection and their efforts should be applauded.
For more information on SWPP efforts and information, please contact Kelly Hon, MRWA Source Water Protection Specialist at 989-621-2361 or khon@mrwa.net.










NEW TANKS (270) 826-9000 ext. 260 5
EXISTING T ANKS (270) 826-9000 ext. 4601








milansupply.com valleyfarmssupply.com


Water Solutions Unlimited has been in business for over 30 years mastering water treatment and troubleshooting to assure the best quality water for your town.
✔ On-site testing and treatment for drinking water
✔ On-site testing and treatment for wastewater
✔ Industrial commodities
✔ Disinfection by-products solutions
✔ Agricultural chemicals
✔ Corrosion control studies
All of our water specialists are trained to work with you to develop a water program that works best for your system!


Letters regarding the assistance you have received from MRWA are useful in discussing with our lawmakers the need for water programs for small communities. If you have received assistance from MRWA that has been helpful, please consider writing a letter of thanks and sending it to us.

7008 Marsh Road
Cottrellville Twp., MI 48039 (810) 765-4730 www.cottrellvilletwp.org
Date: May 27, 2025

John Holland, Michigan Rural Water Association 2127 University Park Drive, Suite 340 Okemos, Mi 48864
Dear Mr. Holland and the Michigan Rural Water Association Team,
Office Hours
Mon/Wed: 9:00 a.m. – 5:00 p.m.
Tues/Thurs: 8:00 a.m. – 12:00 p.m. Friday: Closed
On behalf of myself, Greg Abbey, Supervisor of Cottrellville Township, along with our Department of Public Works team – Nick Jarskey and Chris Hiltunen – and the entire township, I would like to extend our sincere gratitude for your outstanding assistance in locating the persistent water leak that had challenged us for over a year.
Your expertise, dedication, and the resources you provided were instrumental in identifying and resolving this long-standing issue. The impact of your support cannot be overstated – it brought a resolution to a problem that had eluded detection and helped us restore confidence in our water system.
We are truly grateful for your commitment to serving rural communities and for being such a dependable partner in times of need. Your efforts made a real difference in Cottrellville Township, and we deeply appreciate your role in helping us through this crisis.
With heartfelt thanks,
Greg Abbey, Supervisor, Cottrellville Township
On behalf of Nick Jarskey, Chris Hiltunen, and the entire Cottrellville Township community

Thank you
Ron Mastriciano <onsted2@frontier.com>
To: John Holland <jholland@mrwa.net>, Joseph Vandommelen <jvandommelen@mrwa.net>
Dear John and Joe,
On behalf of the Village of Onsted, I would like to extend our sincere thanks to both of you for your invaluable assistance at our wastewater and water treatment plant. Your knowledge, expertise, and dedication have made a significant impact on the operations here, and we are incredibly grateful for the support you’ve provided.
Our employees have greatly benefited from your insights and the education you’ve shared, and we can already see the positive changes in our daily operations. The service you provide through Michigan Rural Water is an asset to our community, and we’re fortunate to have access to such professional resources that truly make a difference in Michigan communities.
Once again, thank you for your hard work and for helping us ensure the ongoing success of our water and wastewater systems. We look forward to continued collaboration with Michigan Rural Water Association.
Thank you,
Ron Mastriciano, Superintendent, Village of Onsted O: 517-467-7042 | M: 419-601-3382
"The quality of your life is determined by the quality of your relationships. The quality of your business is no different." – Harvey Mackay
Letters regarding the assistance you have received from MRWA are useful in discussing with our lawmakers the need for water programs for small communities. If you have received assistance from MRWA that has been helpful, please consider writing a letter of thanks and sending it to us.

Village of Roscommon
Tammy Menghini <assistant@roscommonvillage.com>
To: Tim Neumann <tneumann@mrwa.net>
Good Afternoon Tim,
My name is Tammy Menghini and I am the Administrative Assistant for the Village of Roscommon. I have had the pleasurer of working with one of your employees, Jonathon Edwards, on our water study project recently and I had to let someone know how impressed I was with Jonathon.
As I was the person to get Jonathon the information for the study, which can be cumbersome and time consuming, it truly wasn't. Jonathon presented the information needed in a way I understood and was so patient with me to find this information. Taking the time to explain why he needed it and what he needed it for. Going over reports that were what he needed or not even close lol. Giving me more understanding of how and why a water study report works. I am just so impressed with his character and his professionalism.
Thank you for your time!
Tammy Menghini, Administrative Assistant Village of Roscommon assistant@roscommonvillage.com 989-275-5743 ext 3














As we continue to deliver valuable information through the pages of this magazine, in a printed format that is appealing, reader-friendly and not lost in the proliferation of electronic messages that are bombarding our senses, we are also well aware of the need to be respectful of our environment. That is why we are committed to publishing the magazine in the most environmentally-friendly process possible. So enjoy this magazine... and keep thinking green.


















CLARIFIER is made possible by the companies that convey their important messages on our pages. We thank them for their support of the Michigan Rural Water Association and its publication, and encourage you to contact them when making your purchasing decisions. To make it easier to contact these companies, we have included the page numbers of their advertisements, their phone numbers, and, where applicable, their websites.
Dixon Engineering, Inc.
Haviland
Hawkins Water Treatment
Headwater Companies
JETT Pump & Valve, LLC





•































